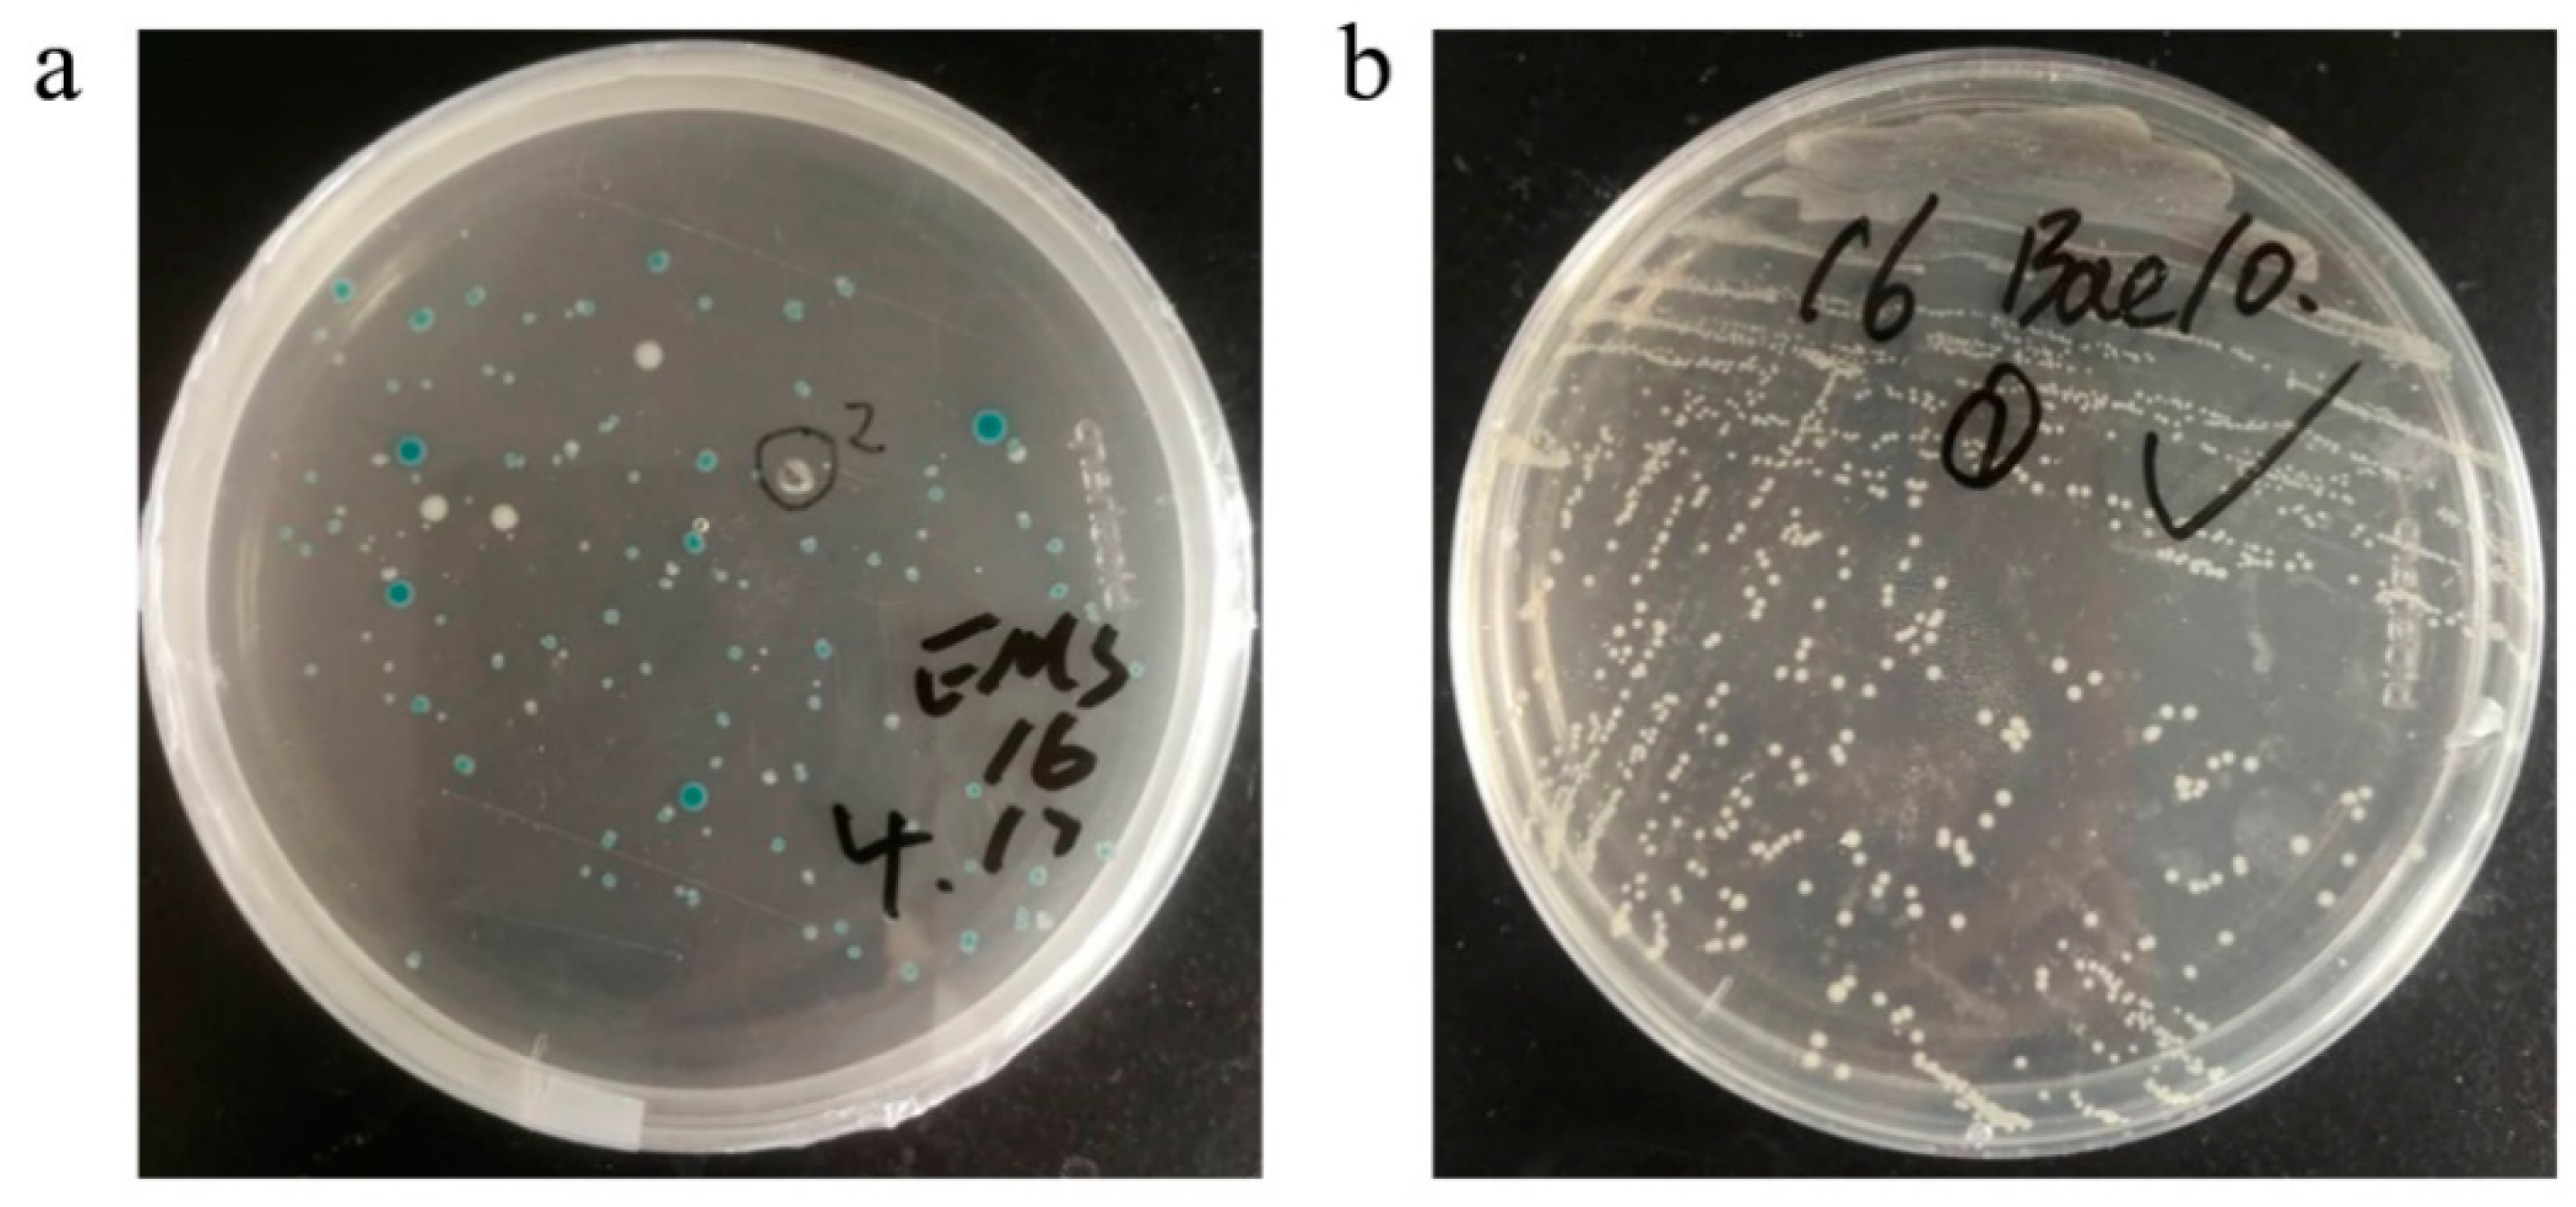
Vaccines 09 00554 g002 Vaccines 09 00554 g002

Production of SARS-CoV-2 Virus-Like Particles in Insect Cells
Abstract
1. Introduction
2. Materials and Methods
2.1. Cell Lines
2.2. Construction of the EMS Triple Expression Plasmid
2.3. Generation of Recombinant Baculovirus
2.4. Preparation of EMS VLPs
2.5. Western Blot Analysis
2.6. Electron Microscopy
3. Results
3.1. Construction of EMS Triple Expression Plasmid
3.2. Generation of Recombinant Bacmid DNA
3.3. Recombinant Baculovirus Production
3.4. Production and Characterization of SARS-CoV-2 VLPs
4. Discussion
Author Contributions
Funding
Institutional Review Board Statement
Informed Consent Statement
Data Availability Statement
Acknowledgments
Conflicts of Interest
References
- Gralinski, L.E.; Menachery, V.D. Return of the Coronavirus: 2019-nCoV. Viruses 2020, 12, 135. [Google Scholar] [CrossRef]
- Han, Q.; Lin, Q.; Jin, S.; You, L. Recent insights into 2019-nCoV: A brief but comprehensive review. J. Infect. 2020, 80, 373–377. [Google Scholar] [CrossRef] [PubMed]
- Zhu, N.; Zhang, D.; Wang, W.; Li, X.; Yang, B.; Song, J.; Zhao, X.; Huang, B.; Shi, W.; Lu, R.; et al. A Novel Coronavirus from Patients with Pneumonia in China, 2019. N. Engl. J. Med. 2020, 382, 727–733. [Google Scholar] [CrossRef] [PubMed]
- WHO. Weekly Epidemiological and Operational Updates April 2021. 2021. Available online: https://www.who.int/emergencies/diseases/novel-coronavirus-2019/situation-reports (accessed on 16 April 2021).
- Lu, H. Drug treatment options for the 2019-new coronavirus (2019-nCoV). Biosci. Trends 2020, 14, 69–71. [Google Scholar] [CrossRef] [PubMed]
- Zhao, J.; Zhao, S.; Ou, J.; Zhang, J.; Lan, W.; Guan, W.; Wu, X.; Yan, Y.; Zhao, W.; Wu, J.; et al. COVID-19: Coronavirus Vaccine Development Updates. Front. Immunol. 2020, 11, 602256. [Google Scholar] [CrossRef] [PubMed]
- Soleimanpour, S.; Yaghoubi, A. COVID-19 vaccine: Where are we now and where should we go? Expert Rev. Vaccines 2021, 20, 23–44. [Google Scholar] [CrossRef]
- Walsh, E.E.; Frenck, J.; Robert, W.; Falsey, A.R.; Kitchin, N.; Absalon, J.; Gurtman, A.; Lockhart, S.; Neuzil, K.; Mulligan, M.J.; et al. Safety and Immunogenicity of Two RNA-Based Covid-19 Vaccine Candidates. N. Engl. J. Med. 2020, 383, 2439–2450. [Google Scholar] [CrossRef]
- Sahin, U.; Muik, A.; Derhovanessian, E.; Vogler, I.; Kranz, L.M.; Vormehr, M.; Baum, A.; Pascal, K.; Quandt, J.; Maurus, D.; et al. COVID-19 vaccine BNT162b1 elicits human antibody and T H 1 T cell responses. Nature 2020, 586, 594–599. [Google Scholar] [CrossRef]
- Rémy, V.; Largeron, N.; Quilici, S.; Carroll, S. The economic value of vaccination: Why prevention is wealth. J. Mark. Access Health Policy 2015, 3. [Google Scholar] [CrossRef]
- WHO. DRAFT Landscape of COVID-19 Candidate Vaccines. 2021. Available online: https://www.who.int/who-documents-detail/draft-landscape-of-covid-19-candidate-vaccines (accessed on 19 April 2021).
- Liu, C.; Zhou, Q.; Li, Y.; Garner, L.V.; Watkins, S.P.; Carter, L.J.; Smoot, J.; Gregg, A.C.; Daniels, A.D.; Jervey, S.; et al. Research and Development on Therapeutic Agents and Vaccines for COVID-19 and Related Human Coronavirus Diseases. ACS Cent. Sci. 2020, 6, 315–331. [Google Scholar] [CrossRef]
- van Riel, D.; de Wit, E. Next-generation vaccine platforms for COVID-19. Nat. Mater. 2020, 19, 810–812. [Google Scholar] [CrossRef]
- Nooraei, S.; Bahrulolum, H.; Hoseini, Z.S.; Katalani, C.; Hajizade, A.; Easton, A.J.; Ahmadian, G. Virus-like particles: Preparation, immunogenicity and their roles as nanovaccines and drug nanocarriers. J. Nanobiotechnol. 2021, 19, 59. [Google Scholar] [CrossRef] [PubMed]
- Chung, Y.H.; Cai, H.; Steinmetz, N.F. Viral nanoparticles for drug delivery, imaging, immunotherapy, and theranostic applications. Adv. Drug Delivery Rev. 2020, S0169-409X, 30070–30073. [Google Scholar] [CrossRef]
- Mohsen, M.O.; Zha, L.; Cabral-Miranda, G.; Bachmann, M.F. Major findings and recent advances in virus-like particle (VLP)-based vaccines. Semin. Immunol. 2017, 34, 123–132. [Google Scholar] [CrossRef] [PubMed]
- Roden, R.B.S.; Stern, P.L. Opportunities and challenges for human papillomavirus vaccination in cancer. Nat. Rev. Cancer 2018, 18, 240–254. [Google Scholar] [CrossRef] [PubMed]
- Stanley, M. Tumour virus vaccines: Hepatitis B virus and human papillomavirus. Philos. Trans. R. Soc. Lond. Ser. B 2017, 372, 20160268. [Google Scholar] [CrossRef]
- Mortola, E.; Roy, P. Efficient assembly and release of SARS coronavirus-like particles by a heterologous expression system. FEBS Lett. 2004, 576, 174–178. [Google Scholar] [CrossRef] [PubMed]
- Wang, C.; Zheng, X.; Gai, W.; Zhao, Y.; Wang, H.; Wang, H.; Feng, N.; Chi, H.; Qiu, B.; Li, N.; et al. MERS-CoV virus-like particles produced in insect cells induce specific humoural and cellular imminity in rhesus macaques. Oncotarget 2017, 8, 12686–12694. [Google Scholar] [CrossRef] [PubMed]
- Chan, J.F.-W.; Kok, K.-H.; Zhu, Z.; Chu, H.; To, K.K.-W.; Yuan, S.; Yuen, K.-Y. Genomic characterization of the 2019 novel human-pathogenic coronavirus isolated from a patient with atypical pneumonia after visiting Wuhan. Emerg. Microbes Infect. 2020, 9, 221–236. [Google Scholar] [CrossRef]
- National Microbiology Data Center of China. Electron Micrograph of Wuhan Strain 01-02 of Novel Coronavirus. 2020. Available online: http://www.nmdc.cn/nCoV (accessed on 9 August 2020).
- Lu, X.; Chen, Y.; Bai, B.; Hu, H.; Tao, L.; Yang, J.; Chen, J.; Chen, Z.; Hu, Z.; Wang, H. Immune responses against severe acute respiratory syndrome coronavirus induced by virus-like particles in mice. Immunology 2007, 122, 496–502. [Google Scholar] [CrossRef]
- Xu, R.; Shi, M.; Li, J.; Song, P.; Li, N. Construction of SARS-CoV-2 Virus-Like Particles by Mammalian Expression System. Front. Bioeng. Biotechnol. 2020, 8, 862. [Google Scholar] [CrossRef]
- Plescia, C.B.; David, E.A.; Patra, D.; Sengupta, R.; Amiar, S.; Su, Y.; Stahelin, R.V. SARS-CoV-2 viral budding and entry can be modeled using BSL-2 level virus-like particles. J. Biol. Chem. 2020, 296, 100103. [Google Scholar] [CrossRef]
- Swann, H.; Sharma, A.; Preece, B.; Peterson, A.; Eldredge, C.; Belnap, D.M.; Vershinin, M.; Saffarian, S. Minimal system for assembly of SARS-CoV-2 virus like particles. Sci. Rep. 2020, 10, 21877. [Google Scholar] [CrossRef]
- Fuenmayor, J.; Gòdia, F.; Cervera, L. Production of virus-like particles for vaccines. New Biotechnol. 2017, 39, 174–180. [Google Scholar] [CrossRef]
- Durous, L.; Rosa-Calatrava, M.; Petiot, E. Advances in influenza virus-like particles bioprocesses. Expert Rev. Vaccines 2019, 18, 1285–1300. [Google Scholar] [CrossRef] [PubMed]
- Zhao, Y.; Li, Z.; Zhu, X.; Cao, Y.; Chen, X.; Zhao, Y.; Li, Z.; Zhu, X.; Cao, Y.; Chen, X. Improving Immunogenicity and Safety of Flagellin as Vaccine Carrier by High-Density Display on Virus-Like Particle Surface. Biomaterials 2020, 249, 120030. [Google Scholar] [CrossRef] [PubMed]
- Tamminen, K.; Heinimäki, S.; Vesikari, T.; Blazevic, V.; Tamminen, K.; Heinimäki, S.; Vesikari, T.; Blazevic, V. Rotavirus VP6 Adjuvant Effect on Norovirus GII.4 Virus-Like Particle Uptake and Presentation by Bone Marrow-Derived Dendritic Cells In Vitro and In Vivo. J. Immunol. Res. 2020, 2020, 3194704. [Google Scholar] [CrossRef] [PubMed]
- Qian, C.; Liu, X.; Xu, Q.; Wang, Z.; Chen, J.; Li, T.; Zheng, Q.; Yu, H.; Gu, Y.; Li, S.; et al. Recent Progress on the Versatility of Virus-Like Particles. Vaccines 2020, 8, 139. [Google Scholar] [CrossRef]
- Naupu, P.N.; van Zyl, A.R.; Rybicki, E.P.; Hitzeroth, I.I. Immunogenicity of Plant-Produced Human Papillomavirus (HPV) Virus-Like Particles (VLPs). Vaccines 2020, 8, 740. [Google Scholar] [CrossRef]
- Matsuda, T.; Tanijima, T.; Hirose, A.; Masumi-Koizumi, K.; Katsuda, T.; Yamaji, H. Production of influenza virus-like particles using recombinant insect cells. Biochem. Eng. J. 2020, 163, 107757. [Google Scholar] [CrossRef]
- Ji, M.; Zhu, J.; Xie, X.-X.; Liu, D.-Q.; Wang, B.; Yu, Z.; Liu, R.-T.; Ji, M.; Zhu, J.; Xie, X.-X.; et al. A Novel Rapid Modularized Hepatitis B Core Virus-Like Particle-Based Platform for Personalized Cancer Vaccine Preparation via Fixed-Point Coupling. Nanomed. Nanotechnol. Biol. Med. 2020, 28, 102223. [Google Scholar] [CrossRef] [PubMed]

| Genes | Size of PCR Product | Primers | Sequence (5′-3′) |
|---|---|---|---|
| E | 228 bp | EF | ATGTACTCATTCGTTTCGGA |
| ER | TTAGACCAGAAGATCAGGAACTC | ||
| M | 669 bp | MF | ATGGCAGATTCCAACGGTA |
| MR | TTACTGTACAAGCAAAGCAATATT | ||
| S | 3819 bp | SF | ATGTTTGTTTTTCTTGTTTTATTG |
| SR | TTATGTGTAATGTAATTTGACTCCTTT | ||
| S’ | 1486 bp | S’F | AAACACGCTTGTTAAACAAC |
| M13R | CAGGAAACAGCTATGAC |
Publisher’s Note: MDPI stays neutral with regard to jurisdictional claims in published maps and institutional affiliations. |
© 2021 by the authors. Licensee MDPI, Basel, Switzerland. This article is an open access article distributed under the terms and conditions of the Creative Commons Attribution (CC BY) license (https://creativecommons.org/licenses/by/4.0/).
Share and Cite
Mi, Y.; Xie, T.; Zhu, B.; Tan, J.; Li, X.; Luo, Y.; Li, F.; Niu, H.; Han, J.; Lv, W.; et al. Production of SARS-CoV-2 Virus-Like Particles in Insect Cells. Vaccines 2021, 9, 554. https://doi.org/10.3390/vaccines9060554
Mi Y, Xie T, Zhu B, Tan J, Li X, Luo Y, Li F, Niu H, Han J, Lv W, et al. Production of SARS-CoV-2 Virus-Like Particles in Insect Cells. Vaccines. 2021; 9(6):554. https://doi.org/10.3390/vaccines9060554
Chicago/Turabian StyleMi, Youjun, Tao Xie, Bingdong Zhu, Jiying Tan, Xuefeng Li, Yanping Luo, Fei Li, Hongxia Niu, Jiangyuan Han, Wei Lv, and et al. 2021. "Production of SARS-CoV-2 Virus-Like Particles in Insect Cells" Vaccines 9, no. 6: 554. https://doi.org/10.3390/vaccines9060554
APA StyleMi, Y., Xie, T., Zhu, B., Tan, J., Li, X., Luo, Y., Li, F., Niu, H., Han, J., Lv, W., & Wang, J. (2021). Production of SARS-CoV-2 Virus-Like Particles in Insect Cells. Vaccines, 9(6), 554. https://doi.org/10.3390/vaccines9060554

